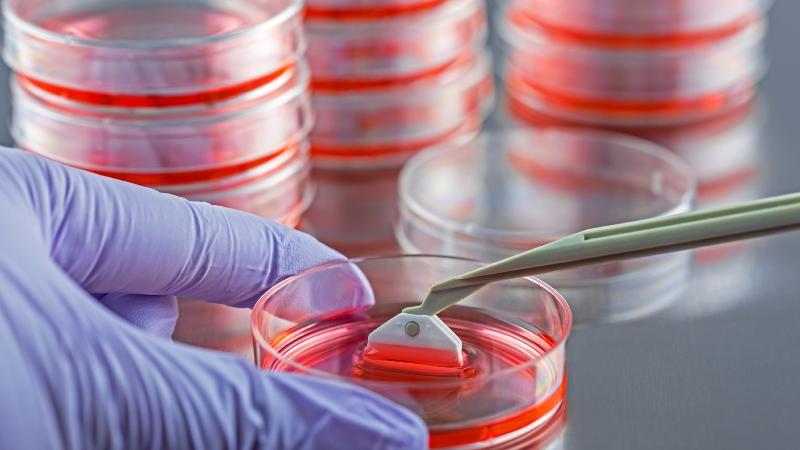

Există posibilitatea ca în viitor sa putem recolta celule stem din piele
Cercetătorii de la University of Jerusalem au reușit să transforme celule din pielea unor rozătoare în celule stem. Această cercetare va deveni cu siguranță un punct de referință pentru această nișă, deoarece va deschide noi căi pentru crearea de noi leacuri și soluții medicale.
În 2006, cercetătorii japonezi au descoperit capacitatea celulelor pielii de a fi „reprogramate” în celule embrionare timpurii care pot genera un întreg făt, prin exprimarea a patru gene embrionare centrale. Aceste celule de piele reprogramate, denumite „Induced Plutipotent Stem Cells” (iPSCs), sunt similare cu celulele care se dezvoltă în primele zile după fertilizare și aproape identice cu omologii lor naturali.
Echipa de la Universitatea ebraică a folosit o nouă tehnologie pentru a examina forțele moleculare care trasează „deciziile” celulare pentru reprogramarea celulelor pielii și procesul natural de dezvoltare embrionară. Pentru a descoperi mecanismele moleculare activate în timpul formării acestor diferite tipuri de celule, cercetătorii au analizat modificările structurii genomului ce funcționează în interiorul celulelor pielii când au fost introduse cele cinci gene. De exemplu, cercetătorii au observat că gena Eomes influențează identitatea și dezvoltarea placentară a celulelor stem placentare, în timp ce gena Esrrb orchestrează dezvoltarea celulelor stem fetale.
Echipa condusă de Dr. Yossi Buganim, a utilizat anumite gene care ar putea transforma celulele pielii de rozatoare în celule stem ale embrionului, placentei și țesuturilor extra-embrionare, cum ar fi cordonul ombilical.
Echipa universității a reușit să găsească o nouă combinație de cinci gene care, atunci când sunt introduse în celulele pielii, reprogramează celulele în mod similar. Dar, diferența cheie este că fiecare dintre cele trei tipuri de celule embrionare timpurii au fost exprimate, nu doar cele care compun embrionul.
Procesul a durat aproximativ o lună pentru a fi finalizat și ca apoi rezultatele să fie analizate, iar ulterior prezentate publicului.
Ce înseamnă pentru noi această cercetare?
Până în prezent, alte studii au fost efectuate pentru a încerca să dezvolte un întreg embrion de șoarece fără a utiliza spermatozoizi sau ovule. Toate acestea au folosit tipuri de celule timpurii izolate de embrioni în curs de dezvoltare.
Conform Science Daily, studiul HU este prima încercare de a crea toate cele trei linii celulare principale simultan din celulele pielii. În plus, aceste descoperiri arată că există posibilitatea ca aceste studii să fie efectuate fără să sacrifice „un embrion viu pentru a crea un embrion de eprubetă”.
Printre alte întrebuințări, celulele stem sunt utilizate în prezent pentru creșterea pielii din părul smuls al unui pacient. Aceste celule pot fi izolate și cultivate pentru a crește o foaie epitelială. Această metodă poate ajuta la reducerea necesității de a folosi grefe de piele de la alte persoane, reducând șansele de respingere. De altfel, celulele stem pot fi folosite pentru a genera dopamina – un produs chimic care le lipseste pacientilor care suferă de boala Parkinson. Cu toate acestea, în unele cazuri, pacienții au dezvoltat reacții adverse, ceea ce sugerează prezența unor niveluri foarte ridicate de dopamină sau supra-sensibilizare în această metodă.
Recoltarea de celule stem în România – unde putem apela la astfel de servicii?
LifeSolutions este partenerul exclusiv pe teritoriul României al Vita34, singura bancă privată de celule stem care are și bancă publică. Vita 34 deține certificările GMP (Good Manufacturing Practice) și U.S. FDA, a autorizației Institutului Paul Ehrilch și a camerei sterile.
Mai multe detalii despre Life Solutions puteți găsi în linkul următor. Afla mai multe despre recoltarea celulelor stem.